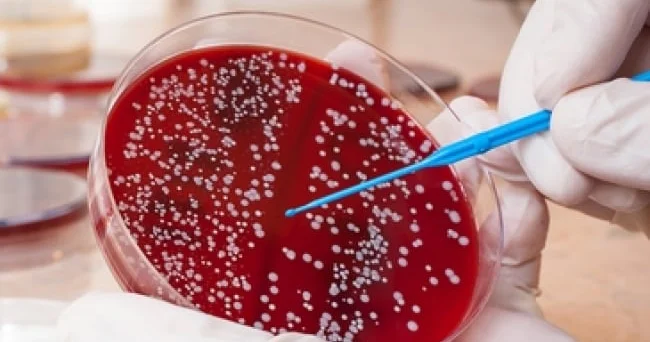
Xərçəngin şirin İzi: Minlərlə insanın həyatı xilas olacaq

Daşkənddə Özbəkistan Pakistan biznes forumu keçirilib
Azertag portalından verilən məlumata görə, Icma.az xəbər yayır.
Bakı, 12 noyabr, AZƏRTAC
Daşkənddə Özbəkistan-Pakistan biznes forumu və Ravalpindi Ticarət və Sənaye Palatasının (RTSP) 36-cı beynəlxalq nailiyyət mükafatlarının təqdimetmə mərasimi keçirilib.
AZƏRTAC Özbəkistanın UzA informasiya agentliyinə istinadla xəbər verir ki, tədbirdə sənaye, kənd təsərrüfatı, əczaçılıq, tekstil, logistika, tikinti, informasiya texnologiyaları, turizm şirkətlərinin nümayəndələri iştirak ediblər.
Forum çərçivəsində bir neçə görüşlər keçirilib. Yekunda birgə istehsal və investisiya layihələrinin həyata keçirilməsinə dair razılaşmalar əldə olunub.
Bu mövzuda digər xəbərlər:Daşkənddə “Özbəkistan Azərbaycan: Əbədi dostluq yolunda” adlı tədbir keçirilib
17 Oktyabr 2025 13:39
Azərbaycan və Özbəkistan Baş nazirləri Daşkənddə görüşüb
11 İyun 2025 13:46
Daşkənddə Azərbaycanla Özbəkistan QHTləri arasında Əməkdaşlıq Memorandumları imzalanıb
05 Dekabr 2024 15:12
Azərbaycanın Baş naziri Daşkənddə Özbəkistan Prezidenti ilə görüşüb
10 İyun 2025 18:25
Türkiyə Azərbaycan Özbəkistan biznes forumu keçirilib
29 Yanvar 2025 16:21
Baxış sayı:41
Bu xəbər 12 Noyabr 2025 10:57 mənbədən arxivləşdirilmişdir



Daxil ol
Xəbərlər
Hava
Maqnit qasırğaları
Namaz təqvimi
Qiymətli metallar
Valyuta konvertoru
Kredit Kalkulyatoru
Kriptovalyuta
Bürclər
Sual - Cavab
İnternet sürətini yoxla
Azərbaycan Radiosu
Azərbaycan televiziyası
Haqqımızda
TDSMedia © 2025 Bütün hüquqlar qorunur







Günün ən çox oxunanları